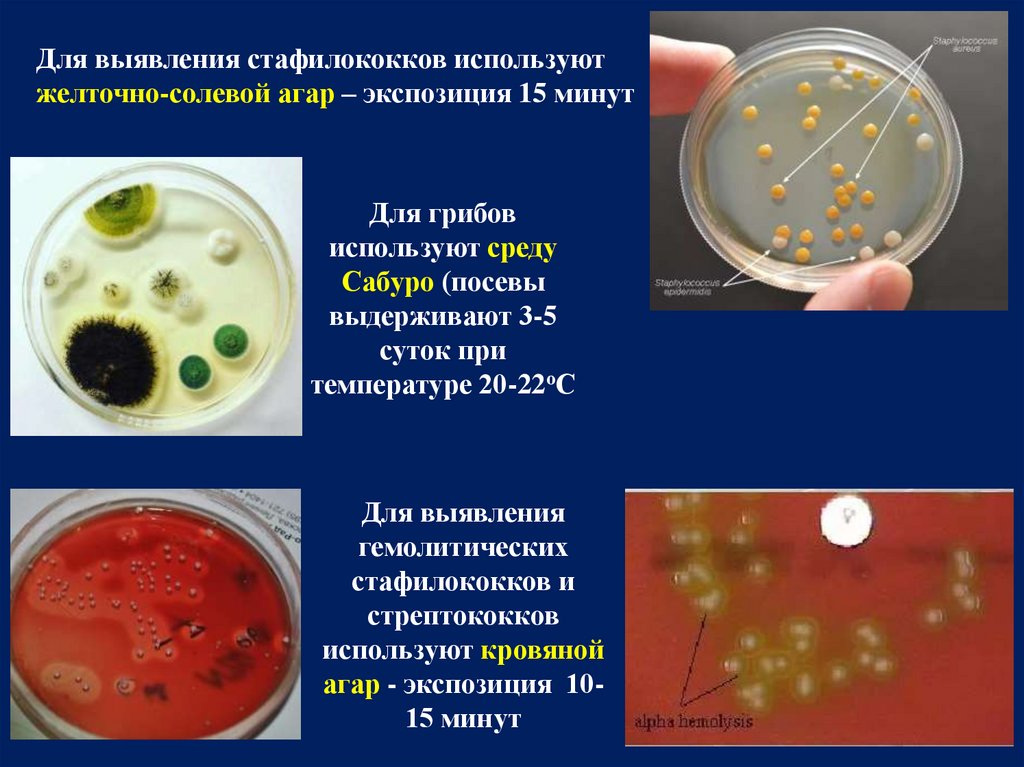
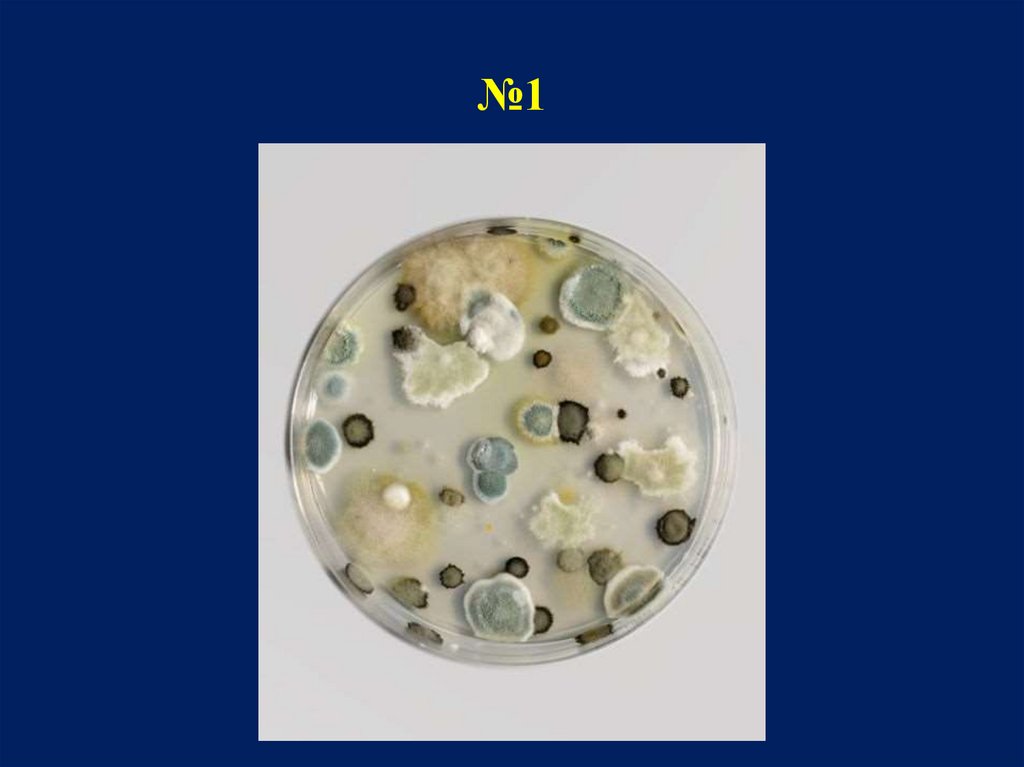
№1
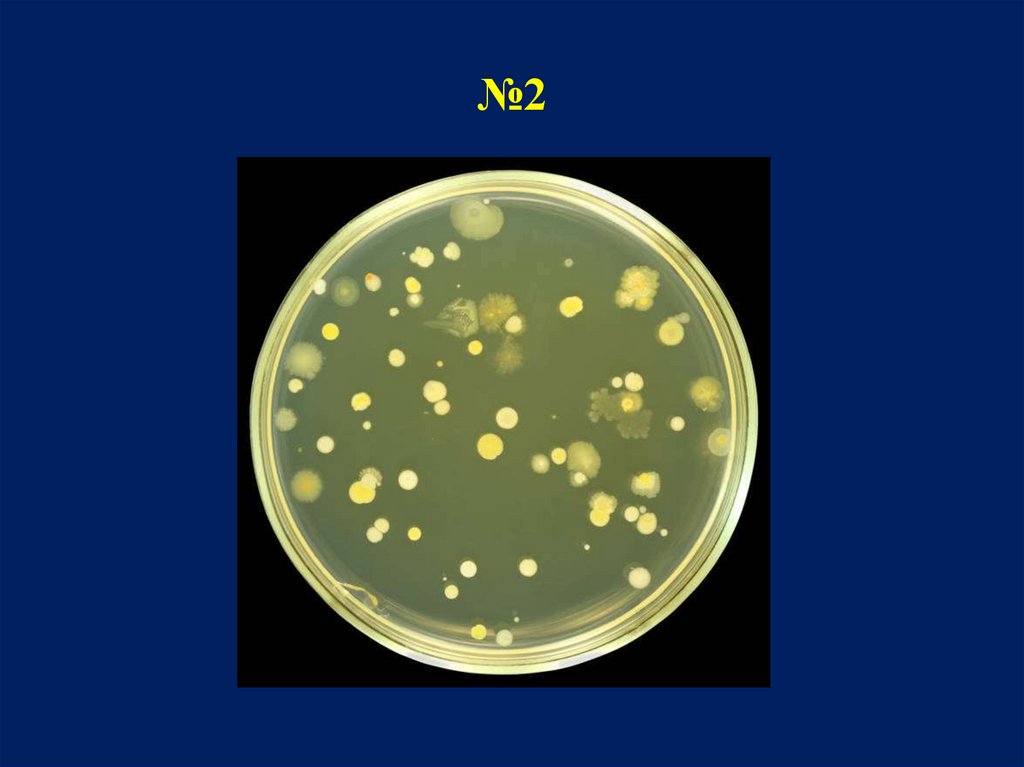
№2
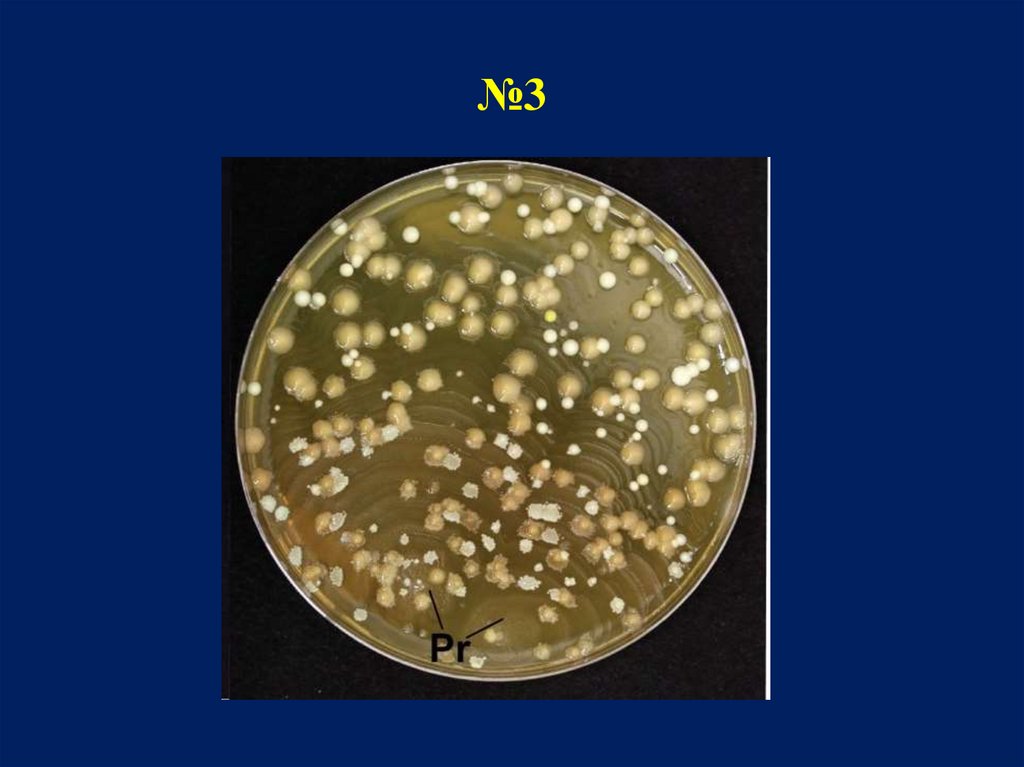
№3
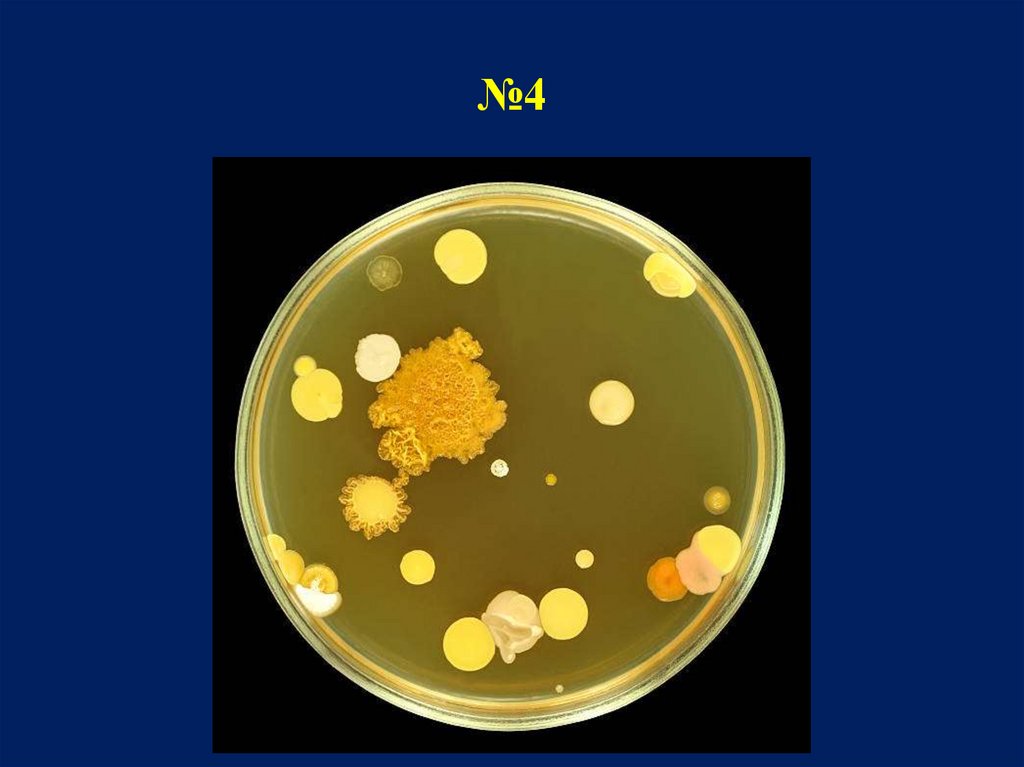
№4

Похожие презентации:
Анализ микрофлоры воздуха. Способы. (3)
1.
Анализ микрофлорывоздуха
2.
Для оценки санитарного состояния воздухазакрытых помещений определяют :
Общее микробное число
Количество санитарно-показательных
микроорганизмов, к которым относятся
гемолитические стафилококки, α- и βгемолитические стрептококки
Количество плесневых и дрожжеподобных
грибов
3.
СЕДИМЕНТАЦИОННЫЙ МЕТОД КОХАМетод основан на спонтанном оседании микроорганизмов под действием силы
тяжести на поверхности питательной среды открытой чашки Петри.
Для определения общего микробного числа две чашки
Петри со стерильным МПА оставляют открытыми в
течение 10-30 минут. Затем их закрывают подписывают и
инкубируют в термостате. Затем посевы выдерживают 24
часа при комнатной температуре для выявления плесневых
грибов. Через 48 часов подсчитывают суммарное
количество колоний, выросших на чашках. Исходят из
того, что за 5 мин на поверхность 100 см2 плотной среды
оседают бактерии из 10 л воздуха (Омелянский В.Л.)
Чашки помещают
в термостат 37°С,
24 часа
4.
Для выявления стафилококков используютжелточно-солевой агар – экспозиция 15 минут
Для грибов
используют среду
Сабуро (посевы
выдерживают 3-5
суток при
температуре 20-22оС
Для выявления
гемолитических
стафилококков и
стрептококков
используют кровяной
агар - экспозиция 1015 минут
5.
АСПИРАЦИОННЫЙ МЕТОДАппарат Кротова для
взятия проб воздуха
Устройство автоматического отбора проб воздуха
ПУ-1Б
На площадку прибора устанавливают открытую чашку Петри с
питательной средой, закрывают крышкой аппарата и включают
мотор. Вращением центробежного вентилятора воздух засасывается
через клиновидную щель и с силой ударяется о поверхность
питательной среды, на которой оседают микроорганизмы,
равномерно распределяясь по ней. Скорость вращения чашки Петри
регулируется, что позволяет пропускать разный объем воздуха в
минуту, который фиксируется микромонометром. По истечении
заданного времени экспозиции выключают мотор, чашку Петри с
посевом воздуха снимают, закрывают и ставят в термостат.
6. Определение общего микробного числа
Микробное число вычисляют по формуле:а х 1000
Х=
V
А* – количество колоний
V – объем пропущенного через прибор воздуха
1000 – искомый объем воздуха в 1 м3
* Подсчитывают количество колоний в каждой чашке Петри и выводят
среднеарифметическое значение
7. Задание по анализу микрофлоры воздуха
1. По внешнему виду колоний на чашках Петриопределить, где была отобрана проба воздуха:
- на улице
- в освещенном проветриваемом помещении
- непроветриваемом помещении
- в подвальном или нежилом сыром помещении
2. Подсчитать число колоний на чашках и
определить количество микроорганизмов в
1кубическом метре воздуха, если посев
производили аспирационным методом из объема
10 литров (используя слайд №6)

Биология
Биология








